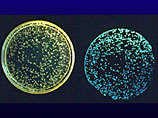

|
 |
 |
 |
| ||||||||||||
 |
Вокруг света
Ученые создали светящееся дерево, способное заменить уличные фонари
3:19PM Thursday, Jan 27, 2011
Светящееся дерево удалось создать британским специалистам из Кембриджского университета. Ученые встроили в генетический код растения структуры, вызывающие флуоресцентное свечение насекомых - светлячков, а также морской бактерии Vibrio fischeri. В результате подобное генетически измененное дерево начинает светиться. При этом силу свечения можно регулировать также с помощью новейших биотехнологий. По мнению британских ученых, новейшее поколение техногенных деревьев способно решить проблему освещения городских улиц и площадей, сообщает ИТАР-ТАСС. В конце 2010 года сообщалось, что студентам Кембриджского университета (Великобритания) удалось получить генетически модифицированных светлячков и морскую бактерию Vibrio fischeri, в организме которых производство светящихся ферментов идет очень быстрыми темпами. Часть генома, отвечающая за свечение, была затем пересажена кишечной палочке. Более того, студенты научились получать различные цвета. В итоге экспериментаторы добились того, что бактериальная колония размером с винную бутылку дает достаточно света для чтения, сообщал сайт "Компьюлента". Главная проблема такого подхода связана с тем, что он основан на люциферинах. Эти вещества, излучив свет, превращаются в оксилюциферин. Кембриджские исследователи смогли так подобрать гены, чтобы организм мог вырабатывать ферменты для переработки последнего. Ученые подсчитали, что организмам потребуется всего 0,02% энергии, полученной в ходе фотосинтеза, для создания конкуренции нынешнему уличному освещению. А за несколько дней до наступления 2011 года сообщалось, что специалисты из Университета Кембриджа пытаются создать ель, которая будет светиться сама - без гирлянд из лампочек, причем не менее ярко и красочно.
По материалам NewsRu.com
Другие новости по теме
• Американцы передали Германии задержанного в Афганистане гражданина ФРГ…• Эксперты спрогнозировали 5-ти процентный рост цен на коттеджи… • Объем строительства офисов в Москве упал на 60 процентов… • Пропавший кот вернулся домой кастрированным… • Последний телохранитель Гитлера перестал отвечать на письма поклонников… • В Интернет выложили крупнейший фотоархив по Холокосту… • Оззи Осборн снялся в рекламе вместе с малолетним поп-певцом… • На новой консоли Sony выйдут Call of Duty и Uncharted… • Британские пенсионеры вновь поженились через 57 лет после развода… • В Германии выявлен британский шпион… • Названы лучшие районы Москвы для проживания с детьми… • В тбилисской гостинице убит гражданин Франции… • Президент Гаити потребовал от своего преемника сняться с выборов… • В США объявились хозяева рояля на отмели… • В коммерческую недвижимость Москвы вложили 3,5 миллиарда долларов… • Немецкая свинина с диоксином признана безвредной…
|
| News Central Home | News Central Resources | Portal News Resources | Help | Login |